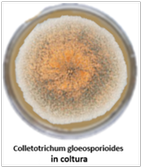

I Funghi
MENU
MALATTIE CRITTOGAMICHE (da FUNGHI)

Caratteristica comune di tutti i Funghi è quella di possedere una struttura cellulare detta Micelio a sua volta costituito da un intreccio di Ife che possono presentare dei setti oppure esserne prive (ife cenocitiche). Le ife hanno il compito di assorbire gli elementi nutritivi.Un’altra caratteristica comune a molti Funghi è quella di riprodursi sessualmente e asessualmente tramite spore che si formano all’interno di una sacca detta Sporangio,a sua volta originato da alcune ife del micelio. Alcuni funghi formano le spore all'interno di ife (clamidospore) ed altri sopravvivovo alle condizioni avverse tramite sclerozi, corpuscoli formati da ife strettamente connesse e sclerificate,talvolta di colore scuro.
I Funghi patogeni per le piante si possono classificare come:



1) Oomiceti
Hanno ife non settate e parete con cellulosa al posto della chitina. Non contengono glicogeno come fonte nutritiva di emergenza.La riproduzione asessuata avviene in un corpo fruttifero detto Zoosporangio di forma allungata o globosa,tramite spore (Zoospore) munite di due flagelli di cui uno provvisto di ciglia. Le zoospore sono di due tipi:zoospore primarie o ausiliarie,prodotte dallo zoosporangio,con i flagelli ad una estremità e che formano cisti primarie molto velocemente; zoospore secondarie o principali prodotte dalla germinazione delle cisti primarie, reniformi,con i flagelli emergenti di lato,dotati di elevata mobilità e a loro volta in grado di formare cisti che germinando danno origine ad un micelio. La riproduzione sessuata avviene in un Oogonio tramite Oospore.Dalla fusione del gamete maschile all'interno dell'anteridio e del gamete femminile all'interno delle oospore si formano oospore fecondate dalla cui germinazione ha origine il micelio.
2) Ascomiceti – hanno ife settate ma con un poro centrale che ne permette la continuità pur presentando cristalli proteici detti Corpi di Woronin che lo occludono in caso di necessità.La formazione delle spore (Ascospore) per via sessuale avviene in uno sporangio detto Asco,cilindrico o globoso, che origina da ife specializzate e che può essere costituito da una sola tunica oppure bitunicato. In genere in un asco sono presenti 8 ascospore,oppure multipli e sottomultipli di 4,raramente una sola ascospora.Le ascospore hanno una forma e colore variabile e possono essere provviste o meno di setti. All'apice dell'asco è presente un opercolo o un poro che aprendosi permette la dispersione delle ascospore. A volte gli aschi sono isolati ma più spesso numerosi aschi sono contenuti in un corpo fruttifero originato dalla aggregazione del micelio detto Ascocarpo o ascoma.


L’ascocarpo può essere un:
- Cleistotecio,cioè un corpo fruttifero sferico chiuso, con gli aschi rivolti verso l'interno;un Casmotecio è un cleistotecio modificato tipico dell'Oidio in grado di aprirsi per la presenza di una linea di rottura;
- Peritecio,cioè un corpo fruttifero con un'apertura all’apice (Ostiolo);spesso più periteci confluiscono tra loro
- un Apotecio,cioè un corpo fruttifero a forma di coppa aperta, con gli aschi rivolti verso l'alto nella parte concava.


La riproduzione asessuata avviene tramite la formazione di spore dette conidi prodotte da strutture dette conidiofori a loro volta prodotti da cellule ifali particolari dette conidiogeniche.I conidiofori posssono emergere singolarmente oppure in gruppi formando un conidioma. Un tipo di conidioma è l' Acervulo che si trova più o meno profondamente sotto lo superficie dei tessuti della pianta ospite. Quando gli acervuli sono pieni di conidi,questi vengono rilasciati tramite la lacerazione dei tessuti della pianta. Un altro tipo di conidioma è il Picnidio, a forma di fiasco e che si trova nello stesso tessuto del fungo. I conidi vengono rilasciati attraverso una piccola apertura all'apice detta ostiolo. In alcuni casi il picnidio non forma conidi implicati nella riproduzione asessuata ma spermazi con funzione riproduttiva sessuata.

I conidi si possono formare e distinguere in:
- Conidi tallici - si formano senza che il conidio iniziale presenti allargamenti. Lo sviluppo tallico può essere olotallico se i conidi sono originati dalla trasformazione in conidio dalle porzione apicale di un'ifa oppure tallico-artrica quando un'ifa viene suddivisa da setti che poi si dissolvono rilasciando i conidi.
- Conidi oloblastici - Tutta la parete della cellula conidiogena è implicata nella formazione della parete del conidio. In alcuni ascomiceti i conidi si sviluppano oloblasticamente ma uno stretto canale collega la cellula conidiogena con il conidio in formazione;tale meccanismo è detto tretico e i conidi formati si dicono Poroconidi.
- Conidi enteroblastici - la parete della cellula conidiogena è rigida e si rompe per formare i conidi. Lo sviluppo enteroblastico può essere di tipo fialidico quando i conidi (fialoconidi) si sviluppano in successione a partire dalla base e sono separati da un setto. I conidi possono staccarsi singolarmente o in catene.Lo sviluppo enteroblastico di tipo anellidico si ha quando nella produzione dei conidi (anelloconidi) un piccolo anello si allunga contribuendo al distacco dei conidi.
Dal momento che gli Ascomiceti possono riprodursi sia asessualmente sia sessualmente,il loro ciclo di vita prevede uno stato anamorfo con riproduzione asessuata e uno stato teleomorfo con riproduzione sessuata. I due stati sono morfologicamente assai diversi e ciò ha comportato problemi dal punto di vista tassonomico attribuendo a due specie diverse quello che invece è solo il particolare stato in cui si trova il medesimo fungo.Per esempio,Botrytis cinerea è la forma anamorfica di Sclerotinia fuckeliana e quindi Botrytis e Sclerotinia rappresentano lo stesso fungo in due stadi diversi.



3) Basidiomiceti - hanno ife settate e protuberanze dette giunti a fibbia. Al centro del setto è presente una formazione detta doliporo.La formazione delle spore per via sessuale (basidiospore) avviene in uno sporangio detto basidio.Le basidiospore si formano esternamente al basidio e sono sorrette da sterigmi. La riproduzione asessuale avviene tramite conidi.


Sclerozi - consistono in un aggregato di ife saldamente compattate da una matrice glucanica e sono quasi sempre di colore bruno-nero. Hanno una funzione sia di sopravvivenza alle condizioni avverse anche per anni sia una funzione riproduttiva essendo in grado di germinare. Gli sclerozi possono essere formati da Ascomiceti e Basidiomiceti e possono essere molto piccoli(Microsclerozi) o anche molto grandi (Macrosclerozi). Si possono classificare in base al loro sviluppo:gli Sclerozi liberi,tipici dei Basidiomiceti,si formano a partire dalle ife,diventano scuri e non presentano veri e propri tessuti;gli Sclerozi terminali presentano una struttura aggregata solida,nera,a volte mucillaginosa e inglobante cellule dei tessuti dell'ospite;gli Sclerozi strand type presentano una zona superficiale che forma una cuticola scura e una porzione interna midollare.
Come veicolo di diffusione,gli Sclerozi possono germinare direttamente producendo un micelio,conidi (riproduzione asessuata),ascocarpi e basidiocarpi (riproduzione sessuata).

Clamidospore - Sono cellule riproduttive asessuate,formate all'interno di ife e con membrana spessa (forma di resistenza) ialina o pigmentata. Vengono disperse solo tramite disfacimento delle ife in cui sono contenute. A volte si formano anche negli sporangiofori e/o nei conidi.
Eziologia di una malattia crittogamica


Una malattia fungina (ma anche batterica, virale,ecc.) evolve in diversi stadi:
Contaminazione: il patogeno di trova all'interno degli organi riproduttivi della pianta (semi,tuberi,ecc) oppure viene trasportato dal vento,insetti,attrezzi non disinfettati.
Inoculazione: la spora fungina germina e si insidia nella cellula ospite attraverso gli stomi fogliari,ferite, punture di insetti o negli organi rirpoduttivi del fiore. Il processo implica la formazione di un tubulo appressorio che funge da ventosa,uno stiletto che penetra la parete cellulare e,in alcuni casi, un austorio che assorbe le sostanze nutritive dalla cellula ospite.
Incubazione:è il periodo che intercorre tra l'inoculazione del patogeno e la comparsa dei sintomi.

Malattia: si definisce trofica se compare alla superficie dell'ospite e ne ostacola la fotosintesi;vascolare se ostruisce i vasi linfatici della pianta portandola ad avvizzimento;necrotica se le cellule ospiti vanno appunto incontro a necrosi; litica se il fungo produce enzimi che causano marcescenza;auxonica se il patogeno produce una alterazione ormonale che si traduce in malformazioni e ipertrofie.
Evasione e dispersione: è la diretta conseguenza della riproduzione del patogeno.
I funghi maggiormente responsabili di patologie crittogamiche appartengono a:
OOMICETI

Agenti eziologici della Peronospora
(Peronosporales)
La Peronospora è una patologia crittogamica causata principalmente dagli Oomiceti:
Peronospora spp.
Specie di interesse orticolo - P.belbahrii,P.destructor,
P. farinosa,P.parasitica,P.pisi,P.umbellifarum,P.viciae, P.valerianellae.
Micelio:con ife cenocitiche;Sporangiofori:a crescita determinata e ramificati dicotomicamente, emergenti dagli stomi singolarmente o in gruppi,senza setti,ialini; Sporangi:zoosporangi di forma ovoidale,ialini,che spesso germinano direttamente.

Legati agli sporangiofori tramite sterigmi ricurvi .Riproduzione asessuata:tramite zoospore biflagellate.Riproduzione sessuata:tramite oospore provviste di una parete che ne limita la germinabilità,giallognole e globose.
Phytophthora spp.
Specie di interesse orticolo - P.infestans,P.capsici,P.fragariae,
P.megasperma, P.nicotianae,P.parasitica,P. porri
Micelio:con ife cenobitiche,ialine,ramificate; Sporangiofori:a crescita determinata e con ramificazioni monopodiali,ialini e settati;Sporangi:zoosporangi di forma ovoidale,papillati e di colore ialino; Riproduzione asessuata:tramite zoospore biflagellate;Clamidospore:globose,giallognole.Riproduzione sessuata:tramite oospore sferiche giallognole.


Bremia spp.
Specie di interesse orticolo - B.lactucae
Ife:cenocitiche;Sporangiofori:ramificati dicotomicamente,emergenti dagli stomi singolarmente o in piccoli gruppi;Sporangi:zoosporangi di colore ialino legati agli sporangiofori tramite caratteristici corti sterigmi agganciati ad una formazione a disco.
Riproduzione asessuata:a volte tramite zoospore; Riproduzione sessuata:tramite oospore.

Plasmopara spp.
Specie di interesse orticolo - P.crustosa,P. nivea ,P. petroselini
Ife:cenocitiche;Sporangiofori:ramificati dicotomicamente; Sporangi:zoosporangi di colore ialino;Riproduzione asessuata: tramite zoospore;Riproduzione sessuata:tramite oospore.
Pseudoperonospora spp.
Specie di interesse orticolo - P.cubensis
Micelio:con ife cenobitiche,ialine;Sporangiofori:biramificati con apici sottili e ricurvi,in gruppi o singoli;Sporangi:zoosporangi

ellittici,grigio chiaro o porpora,inseriti singolarmente sugli sporangiofori e con una papilla alla base;Riproduzione asessuata: tramite zoospore biflagellate;Riproduzione sessuata:tramite oospore prodotte raramente,sferiche,giallognole.
Sintomatologia e Ciclo biologico – Gli agenti infettivi della Peronospora causano la comparsa di aree verdognole-giallastre ai margini e all’apice delle foglie che poi convergono diventano prima brune e poi nere. Sulla pagina inferiore appare una polvere bianca mentre sui fusti appaiono delle striature brune.Sui frutti sono presenti macchie olivastre marcescenti e acquose.I tuberi presentano aree depresse brune o porporine.Nell’Aglio e Cipolla causa marciume basale e dei bulbi,la distorsione e clorosi delle plantule e il collasso delle foglie adulte.Nella Carota causa necrosi delle radici.Le oospore o il micelio sopravvivono alle condizioni avverse nei detriti vegetali infettati. Dalla germinazione delle oospore si producono zoospore che germinando su altri ospiti diffondono la malattia,in particolare quando oltre all'umidità si hanno 15-20°C di temperatura.
Albugo spp.

Ife:cenocitiche;Sporangiofori:cilindrici e corti; Sporangi:zoosporangi sferici,ialini, che si sviluppano dalla base dello sporangioforo formando catene che in seguito causano lesioni del tessuto dell'ospite ed emergono come una polvere bianca;Riproduzione asessuata:tramite zoospore biflagellate e in numero di 8 per zoosporangio.Dalle zoospore germina un caratteristico,austorio piccolo e sferico;
Riproduzione sessuata:tramite oospore di colore bruno.
Sintomatologia e Ciclo biologico - Albugo è un parassita obbligato che causa la Ruggine Bianca caratterizzata dalla comparsa di pustole bianche sulle foglie e fusti. Colpisce in particolare le Brassicacee e lo Spinacio. Le oospore o il micelio sopravvivono alle condizioni avverse nei detriti vegetali infettati. Dalle oospore si producono zoospore che germinando su altri ospiti diffondono la malattia,in particolare quando oltre all'umidità si hanno 20°C di temperatura.
Pythiales


Pythium spp.
Specie di interesse orticolo -P.sulcatum, P.aphanidermatum,P.violae.
Ife:cenocitiche,ialine,con molte inclusioni granulari ma possono presentare anche setti;Sporangiofori:filamentosi e simili alle ife;Sporangi:globosi,originanti dal graduale allargamento di vescicole; Riproduzione asessuata:tramite zoospore biflagellate o clamidospore;Riproduzione sessuata:tramite oospore



Sintomatologia e Ciclo biologico-Pythium causa il Marciume radicale che si manifesta nei semi che non riescono a germinare e quelli che germinano producono plantule con stelo imbevuto d'acqua vicino al colletto che provoca il collasso della pianta. Può anche causare marciumi radicali. Colpisce molte orticole, in particolare Barbabietola, Peperone, Cucurbitacee.Nella Carota compaiono cavità bruno-nerastre circondate da un alone pallido che in seguito marciscono. Le condizioni ambientali favorevoli allo sviluppo della malattia sono rappresentate da umidità e 30-35°C di temperatura.
Saprolegniales

Specie di interesse orticolo - A.euteiches, A.raphani
Micelio:con Ife cenocitiche; Sporangi:zoosporangi non distinti dalle ife, stretti con una singola catena di zoospore primarie; Riproduzione asessuata:le zoospore primarie sferiche,raggruppate all’apice dello sporangio,hanno la caratteristica di non essere flagellate e vanno a formare



delle cisti dalle quali originano zoospore secondarie,questa volta biflagellate.Anche le zoospore secondarie formano cisti che germinando producono le ife da cui sorgono gli zoosporangi Riproduzione sessuata:tramite oospore sferiche.
Sintomatologia e Ciclo biologico – Aphanomyces causa il Marciume radicale che si manifesta con necrosi acquosa prima grigia e poi nera delle radici e del colletto delle plantule. In seguiro si ha ingiallimento e avvizzimento delle piante. Le oospore sopravvivono alle condizioni avverse nei detriti vegetali infettati e germinano quando stimolate da secrezioni radicali dell’ospite. Dalle oospore si producono gli zoosporangi con zoospore che germinando su altri ospiti diffondono la malattia,in particolare quando oltre all'umidità si hanno 20-28°C di temperatura.Le zoospore richiedono acqua per migrare verso le radici.
ASCOMICETI
Agenti eziologici dell'Oidio
Erysiphales

Specie di interesse orticolo - E. heraclei,E.cichoracearum,E.betae,E. cruciferarum,E. pisi,E. poligoni, E.umbelliferarum.
Forma anamorfa asessuata – E’ rappresentata da Oidium subg. Pseudoidium Conidiofori:fialidi singole;Conidi: artroconidi ialini,ellittici, uninucleati che si formano a partire dalla base e si distaccano quando se ne forma uno nuovo. Hanno la caratteristica di essere completamente idratati.
Forma teleomorfa sessuata:Aschi:claviformi,in numero di uno o più inseriti nel casmotecio;Ascocarpo:casmotecio globoso,bruno,senza ostiolo,con appendici caratteristiche;Ascospore:in genere in numero di 2-3 per asco (2-8 per E.pisi),ialine,ovali e senza setti
Uncinula spp.
Specie di interesse orticolo - O.fragariae,O. lycopersicum,O. neolycopersicum.
Forma anamorfa asessuata – E’ rappresentata da Oidium subg. Pseudoidium Conidiofori:fialidi singole;Conidi: artroconidi uninucleati che si formano a partire dalla base e si distaccano quando se ne forma uno nuovo.
Hanno la caratteristica di essere completamente idratati.
Forma teleomorfa sessuata:Aschi:claviformi,numerosi inseriti nel casmotecio;Ascocarpo:casmotecio globoso,bruno,senza ostiolo,con appendici caratteristiche uncinate;Ascospore:
Leveillula spp.
Specie di interesse orticolo - L.taurica;O.sicula.
Forma anamorfa asessuata – E’ rappresentata da Oidiopsis
Conidiofori:fialidi singole;Conidi: artroconidi uninucleati a forma di lancia
che si formano a partire dalla base e si distaccano quando se ne forma uno nuovo.Hanno la caratteristica di essere completamente idratati.
Forma teleomorfa sessuata:Aschi:claviformi,numerosi,inseriti nel casmotecio;Ascocarpo:casmotecio globoso,bruno,senza ostiolo,con appendici simili al micelio;Ascospore:
Podosphaera spp.
Specie di interesse orticolo - P.xanthii.
Forma anamorfa asessuata – E’ rappresentata da Oidium subsp.fibroidium
Conidiofori:fialidi singole;Conidi: artroconidi concatenati. Hanno la caratteristica di contenere corpi di fibrosina.
Forma teleomorfa sessuata:Aschi:un solo asco inserito nel casmotecio; Ascocarpo:casmotecio globoso, bruno,senza ostiolo,con appendici ramificate caratteristiche;Ascospore:
Sphaerotheca spp.
Specie di interesse orticolo - S.castanei,S.fuliginea,S. macularis.
Forma anamorfa asessuata – E’ rappresentata da Oidium subsp. fibroidium

Conidiofori:fialidi singole;Conidi: artroconidiconcatenati ed ellittici. Hanno la caratteristica di contenere corpi di fibrosina.
Forma teleomorfa sessuata:Aschi:un solo asco inserito nel casmotecio; Ascocarpo:casmotecio globoso,bruno,senza ostiolo,con appendici simili al micelio;Ascospore: in numero di 8 per asco e contenenti corpi di fibrosina
Sintomatologia e Ciclo biologico - Il Mal bianco o Oidio è caratterizzato da una efflorescenza bianca polverosa che prima è a macchie circolari e poi ricopre tutta la foglia.L’infezione comincia quando le ascospore e/o i conidi vengono trasportati


Pleosporales - Phoma (Leptosphaeria),Ascochyta (Mycosphaerella), Stemphyllium(Pleospora),Alternaria (Lewia),Pyrenochaeta,Corynespora

Specie di interesse orticolo - P. betae,P. arachidicola,P. destructiva, P. valerianellae,P. lingam;L.maculans.
Forma anamorfa asessuata - Conidiofori: picnidio con un ostiolo o due,esteriormente pigmentato; Conidi: ialini,a forma di bastoncello che spesso fuoriescono dall'ostiolo tramite un cirro.
Forma teleomorfa sessuata: è rappresentata da Leptosphaeria,in particolare L.maculans che infetta le Brassicacee.Aschi:allungati,bitunicati e non amiloidi,che si formano in cavità dette asco-loculi. Ascocarpo: pseudotecio conico provvisto di ostiolo. Ascospore: gialle o marroni chiare,fusiformi,con due o più setti.
Sintomatologia e Ciclo biologico – Phoma causa la Gamba nera e Cancro dello stelo, caratterizzati da cancro basale dello stelo, piccole lesioni fogliari e marciume radicale.

Colpisce in particolare le Brassicacee. Nell’Aglio e Cipolla causa la Radice rosa che si manifesta con radici di colora rosa che poi diventano rosse e infine marroni. Il deperimento delle radici causa la crescita stentata della pianta.
Gli pseudoteci e i picnidi si sviluppano durante l'inverno sui residui vegetali e in primavera le ascospore e i conidi prodotti,dispersi dalla pioggia, infettano le foglie attraverso gli stomi.L'infezione si propaga nella pianta causandone la necrosi dei fusti,probabilmente anche grazie alla produzione di micotossine.


Specie di interesse orticolo - A.pisi,A.fabae, A.rabiei,A.pinodes
Forma anamorfa asessuata - Conidiofori:picnidio; Conidi:ialini,in genere con un setto ma a volte senza setti o con 2-3 setti.Fuoriescono dall'ostiolo tramite un cirro.
Forma teleomorfa sessuata: rappresentata da Mycosphaerella(=Didymella).



Corpo fruttifero:pseudotecio globoso con un ostiolo;Aschi:bitunicati, cilindrici; Ascospore:in numero di 8 per asco,ialine e con un setto.
Sintomatologia e Ciclo biologico- Ascochyta causa la Ruggine delle Leguminose che è caratterizzata da macchie viola o nere su steli,foglie,viticci e baccelli.I semi risultano piccoli e deformi;sui baccelli compaiono lesioni circolari bruno scure. Il fungo sopravvive alle condizioni avverse nei detriti vegetali infettati come peritecio,sclerozi o clamidospore. Le condizioni ambientali favorevoli allo sviluppo della malattia sono rappresentate da umidità elevata e lunghi periodi di pioggia.


Stemphylium spp.
Specie di interesse orticolo - S.vesicarium, S.botryosum, S.floridanum,S.lycopercici,S.solanum
Forma anamorfa asessuata - Conidiofori: semplici o con una ramificazione,settati, bruno-gialli;Conidi: obovali,con 1-6 setti trasversali e 1-3 longitudinali, bruni e muriformi,che si sviluppano singolarmente all'apice dei conidiofori
Forma teleomorfa sessuata-rappresentata da Pleospora.



Sintomatologia e Ciclo biologico - Stemphylium causa la Stemfiliosi caratterizzata inizialmente da piccole macchie giallo-brune sulle foglie basali e sugli steli che diventano poi allungate e contornate da un alone rosa. Successivamente il centro delle macchie diventa grigio e poi bruno scuro.Sui frutti compaiono macchie brune con un alone rossastro.


Specie di interesse orticolo - A.alternata, A.alternata f.sp. lycopersici, A.solani, A.brassicae, A.brassicicola, A.raphani, A.porri,A.dauci,A.cucumerina,A.radicina,A.petroselini,A.cucurbitae
Forma anamorfa asessuata - Conidiofori:singoli o in piccoli gruppi,settati e olivastri. In A.porri sono angolosi e bruno chiari;


Conidi:oblunghi o clavati,bruni e muriformi,che si sviluppano singolarmente all'apice dei conidiofori formando lunghe catene collegate tra loro da pori presenti nei setti e attraverso i quali passano le sostanze per formare nuovi conidi all'apice della catena. In A.solani i setti trasversali 9-11,in A.alternata sono 1-6,in A.brassicae sono 16-19,in A.raphani sono 3-7 e in A.porri sono 8-12. I setti longitudinali sono spesso assenti.
Forma teleomorfa sessuata:non rilevata in alcune specie; in altre è rappresentata da Lewia che infetta le Brassicacee e la Pastinaca.
Ascocarpo:pseudotecio nero brillante;Aschi: bitunicati; Ascospore:giallo-brune, muricate,con 5 setti trasversali e 1-2 setti logitudinali nella parte centrale della spora,clavate e concatenate, prodotte all'apice della catena.

Sintomatologia e Ciclo biologico - Alternaria causa la Alternariosi caratterizzata da anellature concentriche o macchie angolari scure sulle foglie seguite da clorosi e necrosi. Nelle Solanacee si manifesta con punteggiature fogliari e necrosi dei fruttiA. porri causa piccole lesioni brune e acquose sugli steli che si allargano e che confluiscono assumendo un colore porporino.Il fungo sopravvive alle condizioni avverse nei detriti vegetali infettati come micelio. L'infezione origina dalla formazione nei detriti dei conidi la cui forma particolare facilita la dispersione tramite il vento.
Le condizioni ambientali favorevoli allo sviluppo della malattia sono rappresentate da umidità e 25-30°C di temperatura.

Specie di interesse orticolo – E. allii.
Forma anamorfa asessuata - Conidiofori: ;Conidi:ovali a volte pià largi alla base o all’apice con uno o senza setti più scuro del resto.
Forma teleomorfa sessuata:
Ascocarpo:;Aschi:; Ascospore:giallo-.
Sintomatologia e Ciclo biologico - Embellisia causa aree scure irregolari alla base dei bulbi,tranne quelli dell'Aglior osso che è immune. Il fungo sopravvive alle condizioni avverse nei detriti vegetali e nel terreno per molti anni.


Specie di interesse orticolo – P. lycopersici,che infesta il Pomodoro , P.tabacinum.
Forma anamorfa asessuata - Conidiofori:fialidi cilindriche all’interno di picnidi scuri e globosi che non sempre si formano; Sclerozi:microsclerozi;Conidi:ialini,dritti o poco ricurvi,senza setti.
Forma teleomorfa sessuata:non rilevata.


Sintomatologia e Ciclo biologico - Pyrenochaeta causa la Radice suberosa caratterizzata da suberificazione delle radici e fessurazioni.I microsclerozi infestano le radici della pianta e, germinando,producono ife che causano la necrosi delle radici. La peculiarità della patologia consiste in una suberificazione delle radici principali che non sono più in grado di assorbire acqua e nutrienti. I nuovi sclerozi che vengono prodotti sopravvivono nel terreno per molti anni.


Specie di interesse orticolo – C. cassiicola.
Forma anamorfa asessuata - Conidiofori:fialidi cilindriche, brune,isolate e settate;Conidi:bruni,dritti o poco ricurvi,con 3-14 pseudosetti.
Forma teleomorfa sessuata: non rilevata
Sintomatologia e Ciclo biologico - Corynespora causa Maculatura fogliare caratterizzata da macchie fogliari con



centro chiaro e margini scuri, nonché fossette scure sui frutti e sui baccelli.i conidi,dispersi dal vento,causano macchie clorotiche fogliari e macchie scure sui frutti.
Capnodiales - Septoria,Cercospora,Cladosporium (Mycosphaerella)


Specie di interesse orticolo - S.apiicola, S.cucurbitacearum, S.lactucae, S.lycopersici, S.pisi S.melongenae,S.petroselini, M.brassicicola, M. fragarie
Forma anamorfa asessuata - Corpo fruttifero:
picnidio subgloboso; Conidi:molto più lunghi che larghi,curvi e plurisettati.



Forma teleomorfa sessuata: è rappresentata da Mycosphaerella. Ascocarpo:pseudotecio piccolo,bruno, globoso,che si sviluppa appena al di sotto dell'epidermide delle foglie;Aschi:bitunicati, in fasci;Ascospore:ialine con un setto.
Sintomatologia e Ciclo biologico - Septoria causa la Septoriosi caratterizzata inizialmente da piccole macchie acquose che diventano poi necrotiche brune e grigie al centro anche in seguito a produzione di micotossine.Nelle lesioni fuoriescono i picnidi e i conidi.

Il fungo infetta anche gli steli e i frutti su cui compaiono macchie scure.Il fungo sopravvive alle condizioni avverse nei detriti vegetali infettati come micelio o come picnidio. L'infezione origina dalla formazione nei detriti dei conidi che vengono trasportati dalla pioggia sulla pagina inferiore delle foglie. In seguito si formano i nuovi picnidi.
Le condizioni ambientali favorevoli allo sviluppo della malattia sono rappresentate da umidità e 20-25°C di temperatura.


Specie di interesse orticolo - C.beticola,C.apii, C.arachidicola, C.armoraciae,C.asparagi, C.capsici,C. carotae, C.fuligena, C.melongenae, C. ocimicola, C.petroselini,C.solani.
Forma anamorfa asessuata - Micelio:ife aeree pigmentate Conidiofori:in fasci,dritti o poco curvi,bruno-giallognoli;Conidi: allungati, ialini,pluri-settati e affusolati.



Forma teleomorfa sessuata - non rilevata in C. beticola (in altre Cercospora è rappresentata da Mycosphaerella).
Sintomatologia e Ciclo biologico - Cercospora causa la Cercosporiosi caratterizzata da piccole macchie circolari necrotiche al centro e rossastre ai margine oppure da macchie grigiastre.In genere attacca le foglie,ma anche steli e frutti.Il fungo sopravvive alle condizioni avverse nei detriti vegetali infettati come micelio dal quale,germinando, vengono prodoti conidi che vengono dispersi dal vento e dalla pioggia.
Le condizioni ambientali favorevoli allo sviluppo della malattia sono rappresentate da umidità elevata e 20-25°C di temperatura. L'infezione colpisce maggiormente le piante esposte al sole rispetto a quelle ombreggiate a causa della fotosintesi di una tossina denominata Cercosporina,che forma specie radicaliche in grado di distruggere le membrane cellulari dell'ospite.
Pseudocercosporella spp.


Specie di interesse orticolo - P.capsellae.
Forma anamorfa asessuata – Conidiofori: in fasci densi, dritti o poco curvi,cilindrici,senza setti,ialini;Conidi: singoli,filiformi con 0-4 setti, ialini,con una estremità tronca caratteristica.
Forma teleomorfa sessuata:non rilevata (probabilmente è rappresentata da Mycosphaerella)
Sintomatologia e Ciclo biologico - Il fungo si manifesta con aree gialle alonate di bruno e si insedia nelle foglie e nei fusti grazie



alla secrezione di enzimi. Sverna come micelio e si sviluppa con clima fresco e umido.


Cladosporium spp.
Specie di interesse orticolo - C.fulvum (=Fulvia fulva),C.cucumerinum,C.allii-cepae,C.variabile.
Forma anamorfa asessuata - Conidiofori:semplici o ramificati,a volte emergenti da uno sclerozio;Conidi: bruni,con 1-3 setti, in catene dal cui apice prendono origine.
Forma teleomorfa sessuata:non rilevata in
C. fulvum (in altri Cladosporium è rappresentata da



Mycosphaerella spp.).
Sintomatologia e Ciclo biologico - Cladosporium provoca la Cladosporiosi caratterizzata da macchie ellittiche sulle foglie,giallo-brunastre,con successivo disseccamento dei tessuti.I conidi infettano le foglie attraverso gli stomi e le ife si sviluppano senza la formazione dell'austorio. Il sacccarosio della pianta viene convertito in mannitolo dal fungo. Le foglie presentano aree clorotiche gialle e a volte i conidiofori emergono sulla pagina inferiore della foglia presentandosi come una polvere marrone chiaro di spore.La muffa ostruisce gli stomi facendo avvizzire le foglie.


Specie di interesse orticolo – R. cynarae,R.beticola, R.phaseolina.
Forma anamorfa asessuata Conidiofori:ialini, cilindrici, eretti,settati,dritti o inclinati,senza ramificazioni ;Conidi: ialini,lisci o poco verrucosi,fusiformi o ellittici,con 0-2 setti, in catene ramificate anche di 9 elementi.



Forma teleomorfa sessuata:non rilevata
Sintomatologia e Ciclo biologico - Ramularia è un parassita obbligato che causa la Maculatura farinosa caratterizzata da una efflorescenza bianca sulla pagina superiore delle foglie mentre sulla pagina inferiore la foglia appare di colore prima giallo e poi bruno.Il fungo sopravvive alle condizioni avverse nei detriti vegetali infettati dal micelio. Tramite la pioggia il micelio germina e si sviluppano i conidi che diffondono l'infezione tramite il vento.
Le condizioni ambientali favorevoli allo sviluppo della malattia sono rappresentate da umidità e 20°C di temperatura.
Glomerellales - Colletotrichum (Glomerella)


Specie di interesse orticolo -C.capsici, C.lindemuthianum,C.coccodes,
C.gloeosporioides,C.higginsianum,
C.acutatum,C.dematium,C.fragariae,
C.lagenarium,C.melongenae,C. orbicolare, C.truncatum.

Forma anamorfa asessuata - Corpo fruttifero:acervulo tondo con sete brune,settate e acute all'apice Conidiofori:fialidi corte,ialine o marrone chiaro, cilindriche,con o senza setti;Conidi: allungati e ricurvi,ialini, senza setti,con apice acuto e base tronca,prodotti in una massa vischiosa dell'acervulo.
Forma teleomorfa sessuata - è rappresentata da Glomerella che infetta le stesse piante della forma anamorfa.Ascocarpo: peritecio scuro con un collo allungato;Aschi:all'interno del peritecio,sottili e ialini; Ascospore: in numero di 8 per asco,rilasciate passivamente dal peritecio.
Sintomatologia e Ciclo biologico - Colletotrichum è un parassita obbligato che
causa l’Antracnosi caratterizzata da lesioni contenenti gli acervuli su varie parti della pianta e piccole macchie sulle foglie che si ingrandiscono e diventano di colore marrone. Nelle Solanacee e nelle Fragole si formano piccole aree marcescenti sui frutti che passano gradualmente dal giallo al bruno e al nero. Nell'Aglio e Cipolla causa macchie nere sui bulbi. I baccelli dei Legumi presentano macchie circolari più scure ai margini.Il fungo sopravvive alle condizioni avverse nei detriti vegetali e nei semi infettati dal micelio. Tramite il vento i conidi diffondono l'infezione.La massa vischiosa dell'acervulo produce sostanze che impediscono la germinazione dei conidi, la quale viene attuata quando la mucillagine viene diluita dalla pioggia.

Le condizioni ambientali favorevoli allo sviluppo della malattia sono rappresentate da umidità e 25°C di temperatura.


Specie di interesse orticolo - V. albo-atrum,V. dahliae,V. longisporum.
Forma anamorfa asessuata – Conidiofori: fialidi erette, con ramificazioni in verticilli,ialine e brune alla base,più strette all’apice,settate; Conidi:ialini,ovali, senza setti, prodotti all’apice delle ramificazioni; presenza di microsclerozi bruni
Forma teleomorfa sessuata-non rilevata.
Sintomatologia e Ciclo biologico - Verticillium causa la Verticillosi o Tracheoverticillosi.Il fungo attacca le



radici e risale nei vasi conduttori provocando necrosi, appassimento e morte.


Specie di interesse orticolo – P. tabacinum (=Fusarium tabacinum); P.cucumerina.
Forma anamorfa asessuata - Conidiofori:fialidi semplici o ramificate,ialine;Conidi:ialini,ellittici,con o senza setti.
Forma teleomorfa sessuata: è rappresentata da Plectosphaerella
Ascocarpo:;Aschi:cilindrici,unitunicati;Ascospore:ialine, ellittiche, con un setto.



Sintomatologia e Ciclo biologico - i conidi vengono trasportati da pioggia e vento e danno origine a piccole macchie bianche fogliari
che convergono e rendono clorotiche le nervature. Le foglie ingialliscono e la pianta avvizisce La patologia può colpire anche i frutti e il fungo può sopravvivere su residui vegetali per molti anni.
Hypocreales - Fusarium (Nectria e Gibberella)


Fusarium spp.
Specie di interesse orticolo - F. oxysporum e diverse forme speciali che infettano molte orticole: F. oxysporum f.sp.lycopersici,F. oxysporum f.sp.pisi,F. oxysporum f.sp. cepae, F. oxysporum f.sp. cucumerinum;F. solani.
Forma anamorfa asessuata - Conidiofori: fialidi singole; Conidi:macroconidi ialini,con 3-5 setti e fusiformi;


Forma teleomorfa sessuata:non rilevata in F. oxysporum e F.solani f.sp.cucurbitae. In Fusarium solani è rappresentata da Nectria haematococca che infetta piante arboreee.In altre specie di Fusarium è rappresentata da Gibberella. Aschi:claviformi;Ascocarpo:peritecio;Ascospore:8 per ciascun asco;ialine e con un setto.

Sintomatologia e Ciclo biologico - Fusarium causa la Tracheofusariosi caratterizzata da ingiallimento delle foglie man mano che vengono emesse e totale avvizzimento della pianta.Sezionando i fusti compare una tipica colorazione bruna del sistema vascolare.Nell'Aglio e Cipolla compare una colorazione rossastra di steli e bulbi che presentano in seguito aree molli acquose.Fusarium causa anche il Marciume basale-radicale delle plantule con macchie necrotiche.Il fungo sopravvive alle condizioni avverse nei detriti vegetali infettati dal micelio e dalle clamidospore. Dopo la germinazione,il fungo si diffonde prima nelle radici e poi nel sistema vascolare ostruendolo. Il materiale propagativo rimane nel terreno anche per tempo indefinito.
Le condizioni ambientali favorevoli allo sviluppo della malattia sono rappresentate da umidità,25°C di temperatura e pH acido del terreno.


Cylindrocladium spp.
Specie di interesse orticolo - C.crotalariae
Forma anamorfa asessuata - Conidiofori: fialidi che emergono ad angolo retto dai tessuti dell’ospite; Conidi:ialini,cilindrici, con 1-3 setti.In alcune specie si producono macroconidi dritti e cilindrici e microconidi cilindrici,dritti o curvi,con un setto.



Forma teleomorfa sessuata- rappresentata da Calonectria Aschi:claviformi;Ascospore:con 1-3 setti prodotte in numero di 8 da un peritecio globoso arancione-rosso.
Sintomatologia e Ciclo biologico -causaremarciume radicale,ingiallimento delle foglie e lesioni dello stelo.Il fungo sopravvive alle condizioni avverse nei detriti vegetali infettati dal micelio e dai microsclerozi. Dopo la germinazione,il fungo si diffonde tramite i conidi e le ascospore.Le condizioni ambientali favorevoli allo sviluppo della malattia sono rappresentate da umidità e pioggia.
Microascales - Thielaviopsis (Ceratocystis)


Thielaviopsis spp.
Specie di interesse orticolo - T. basicola; C.fimbriata
Forma anamorfa asessuata-Conidiofori:fialidi; Conidi:cilindrici e prodotti all'interno della fialide
Forma teleomorfa sessuata - è rappresentata da Ceratocystis che infetta piante arboreee. Ascocarpo:peritecio con un lungo tubulo;Aschi:deliquescenti con conseguente formazione del peritecio; Ascospore:risalgono verso



Sintomatologia e Ciclo biologico - Thielaviopsis causa il Marciume radicale nero caratterizzato da lesioni nere delle radici, ingiallimento della pianta e avvizzimento.La mucillagine del tubulo della forma teleomorfa attrae,grazie a sostanze odorose, gli insetti che disperdono anche le ascospore.
Diaporthales - Phomopsis (Diaporthe)


Specie di interesse orticolo - P. phaseoli,P. obscurans,P.sclerotioides
Forma anamorfa asessuata - Conidiofori:fialidi ialine in un picnidio;Conidi:di due tipi,alfa di forma ovoidale,ialine,senza setti e beta di forma allungata.ialine e settate.
Forma teleomorfa sessuata - è rappresentata da Diaporthe che infetta la vegetazione secca.



Ascocarpo:peritecio scuro con un ostiolo;Aschi:clavati e terminano con un apparato colorabile con iodio; Ascospore:8 per ciascun asco,ialine e con un setto.
Sintomatologia e Ciclo biologico - Phomopsis causa nelle plantule necrosi del colletto,nella pianta sviluppata ingiallimento e caduta delle foglie,nei frutti macchie che si espandono gradualmente. Le lesioni necrotiche sono acquose a causa della produzione di enzimi che dissolvono la parete cellulare.Vengono inoltre prodotte micotossine denominate Fomopsine che uccidono le cellule ospiti. Il fungo sopravvive alle condizioni avverse nei detriti vegetali infettati dal micelio e dai picnidi.I conidi vengono diffusi dalla pioggia.Le condizioni ambientali favorevoli allo sviluppo della malattia sono rappresentate da umidità,26-30°C di temperatura.In particolare a 16°C vengono prodotti i beta conidi e a 26°C gli alfa conidi.
Xylariales - Microdochium,Monosporascus


Specie di interesse orticolo – M. panattonianum.
Forma anamorfa asessuata - Conidiofori:semplici o ramificati;Conidi:ialini,fusiformi,ovoidali o clavati,con 0-1 setti,raramente due.;Clamidospore in lunghe catene
Forma teleomorfa sessuata:è rappresentata da Monographella.
Ascocarpo:;Aschi:; Ascospore:



Patologia –

Specie di interesse orticolo – M. cannonballus
Forma anamorfa asessuata – non rilevata
Patologia - I conidi vengono dispersi dagli insetti. La mucillagine del tubulo della forma teleomorfa attrae,grazie a sostanze odorose,gli insetti che disperdono anche le ascospore.
Forma teleomorfa sessuata: Ascocarpo:peritecio globoso nero; Aschi:numerosi e claviformi
Ascospore: una sola ascospospora bruna o nera sferica per ogni asco.
Saccharomycetales

Specie di interesse orticolo – G.candidum.
Forma anamorfa asessuata - Conidiofori: ialini, difficilmente distinguibili dalle ife;Conidi:sono artroconidi.
Forma teleomorfa sessuata - è rappresentata da Galactomyces
Ascocarpo:Aschi:contengono una sola ascospora e si sviluppano in prossimità dei setti; Ascospore: contengono 1-2 nuclei
Patologia – le piante infettate presentano frutti con lesioni lattiginose.
– causa il Marciume acido che infetta Pomodori , Carote e altre verdure facendo marcire i frutti.
Myriangiales



Specie di interesse orticolo - S.batatas.
Forma anamorfa asessuata - Conidiofori:in un acervulo,corti,semplici o raramente ramificati;Conidi:ialini,oblunghi,senza setti.
Forma teleomorfa sessuata-rappresentata da Elsinoë Aschi: globosi o ovoidali,con 8 spore; Ascospore: ialine con 1-3 setti.

Sintomatologia e Ciclo biologico - Sphaceloma causa lesioni brune su steli e foglie che si arricciano.Dalla confluenza delle lesioni si formano croste.
Helotiales - Botrytis (Sclerotinia)


Specie di interesse orticolo - B. cinerea,B.allii,B. fabae, B.squamosa, S.minor,S.sclerotiorum.
Forma anamorfa asessuata Micelio:ialino,settato e ramificato.
Conidiofori:fialidi scure,in gruppi e ramificate; Conidi:macro-conidi plurinucleati, ellittici e prodotti all'apice delle ramificazioni delle fialidi.Micro-conidi con un solo nucleo prodotti da fialidi a stretto contatto con il micelio.

Forma teleomorfa sessuata: è rappresentata da Sclerotinia,in particolare Sclerotinia sclerotiorum.
Ascocarpo:apotecio localizzato negli stomi fogliari formato da cellule esterne scure e interne ialine; Aschi:bitunicati e cilindrici;Ascospore:in numero di 8 per asco,germinano in primavera originando un micelio che produce piccole fialidi e microconidi.
Sintomatologia e Ciclo biologico - Botrytis provoca la Muffa grigia. Nelle Liliacee compare sul colletto e penetra nei bulbo facendolo marcire oppure si presenta sulle foglie con punti bianchi alonati di verde.Nelle Cucurbitacee, Solanacee e Fragole crea marcescenza dei frutti.
Sclerotinia causa la Muffa bianca caratterizzata dalla comparsa di lesioni brune sullo stelo in prossimità del suolo e aree necrotiche nei piccioli delle foglie basali. Le radici,foglie,infiorescenze e frutti si ricoprono di un micelio bianco.
Gli sclerozi rimangono dormienti in inverno sui tessuti infetti o nel terrreno per poi germinare in primavera originando macroconidi o apoteci. I macroconidi si diffondono tramite il vento e/o insetti e, dopo avere emesso il tubulo, secernono polisacccadi che ancorano saldamente il fungo all'ospite. Con l'emissione dell' appressorio vengono inoculati enzimi che sciolgono la pectina con formazione di necrosi molli. Viene inoltre rilasciato acido ossalico che altera il pH dei tessuti acidificandolo,rendendo più veloce la degradazione della pectina e sottraendo calcio. Dagli sclerozi possono anche formarsi apoteci che danno origine ad aschi con ascospore che germinando a loro volta danno origine a fialidi con microconidi.
Le condizioni ambientali favorevoli allo sviluppo della malattia sono rappresentate da umidità e 15°-20°C di temperatura.

Specie di interesse orticolo - D.carlianum.
Forma anamorfa asessuata - Conidiofori:acervulo e un picnidio in inverno;Conidi:.Rilasciati dal picnidio in primavera
Forma teleomorfa sessuata: rappresentata da Marssonina Aschi: in un apotecio;Ascospore:
Sintomatologia e Ciclo biologico - Diplocarpon causa la Bruciatura fogliare della Fragola caratterizzata da molte piccole lesioni violacee ad area indefinita sulla pagina superiore della foglia.Le foglie diventano marroni e seccano. L'infezione può colpire anche piccioli,steli e frutti.Il fungo sopravvive alle condizioni avverse nei detriti



vegetali infettati dagli acervuli.I conidi vengono diffusi dalla pioggia e danno origine a nuovi acervuli. Il patogeno si propaga abche tramite le ascospore prodotte dagli apoteci.Le condizioni ambientali favorevoli allo sviluppo della malattia sono rappresentate da umidità,20-25°C di temperatura.
Botryosphaeriales


Macrophomina spp.
Specie di interesse orticolo – M. phaseolina,che infesta il Fagiolo e le Cucurbitaceee.
Forma anamorfa asessuata - Conidiofori:emergenti dal micelio ad angolo retto e più stretti alla base; Sclerozi:sono microsclerozi sferici od oblunghi,dal bruno chiaro al nero;Picnidi:raramente presenti,marroni scuro o neri,più larghi degli sclerozi,globosi e con ostiolo; Conidi:fusiformi,senza setti.



Forma teleomorfa sessuata:
Sintomatologia e Ciclo biologico - Macrophomina causa il Marciume carbonioso caratterizzato da lesioni rosse e poi grigie scuro nella parte vicino al colletto. Le piantine giovani muoionoIl fungo sopravvive alle condizioni avverse tramite gli sclerozi che contaminano il terreno.Gli sclerozi,germinando nelle radici dell’ospite,invadono i tessuti vascolari con le loro ife.La porzione basale dei fusti appare grigia per la presenza di nuovi sclerozi.Le condizioni ambientali favorevoli allo sviluppo della malattia sono rappresentate da umidità e 28°C di temperatura.


Specie di interesse orticolo - P.arachidis-hypogaea.
Forma anamorfa asessuata - Conidiofori:picnidio globoso,scuro; Conidi:ialini,ellittici od ovoidali,senza setti.
Forma teleomorfa sessuata: rappresentata da Guignardia Aschi:bitunicati,clavati,all’interno di uno pseudotecio globoso con un ostiolo Ascospore:ellittiche senza setti ialine a volte con una appendice mucillaginosa.


Sintomatologia e Ciclo biologico - Phyllosticta causa macchie gialle con margini marroni che confluendo portano all'avvizimento delle foglie.Il fungo sopravvive alle condizioni avverse tramite i picnidi nei detriti vegetali. I conidi e le ascospore vengono diffuse da vento e pioggia.Le condizioni ambientali favorevoli allo sviluppo della malattia sono rappresentate da umidità e 24-30°C di temperatura.
BASIDIOMICETI
Atheliales


Specie di interesse orticolo - S.rolfsii,S.cepivorum
Forma anamorfa asessuata – Micelio:Ife ialine,sottili, senza giunti a fibbia se giovani.Conidi:non vengono prodotti.Il fungo si riproduce asessualmente tramite sclerozi piccoli e scuri.Gli sclerozi germinando possono produrre microconidi che non possiedono però alcuna funzione.
Forma teleomorfa sessuata - Basidi:ovoidali con 2-4 sterigmi per basidio;Basidiospore:ellittiche o tonde,ialine e senza setti


Sintomatologia e Ciclo biologico - Sclerotium causa Marciume bianco che attacca le radici ricoprendole di un micelio bianco con molti sclerozi scuri. In seguito si ha deperimento fogliare.Il fungo sopravvive alle condizioni avverse tramite gli sclerozi che contaminano il terreno e i detriti vegetali infetti.Gli sclerozi germinano formando ife che infettano le radici delle piante ospiti e la secrezione di enzimi che dissolvono la pectina causa la necrosi.Si formano nuovi sclerozi che possono sopravvivere nel terreno per molti anni. Nell'Aglio e Cipolla si ha prima

ingiallimento delle foglie e successiva comparsa di micelio bianco e sclerozi sui bulbi.La germinazione degli sclerozi viene innescata dalla degradazione batterica di sostanze volatili contenute in Aglio e Cipolla.Le condizioni ambientali favorevoli allo sviluppo della malattia sono rappresentate da umidità e 30°C di temperatura.In S.cepivorum è sufficiente una temperatura di 18°C.
Cantharellales


Specie di interesse orticolo – R. solani, R.violacea,R.fragarie
Ife:inizialmente ialine e poi brune,suddivise tramite setti ma comunicanti tramite un doliporo in mezzo al setto. Le ife secondarie emergono ad angolo retto,sono più ristrette alla base ed hanno in genere più di tre nuclei per ifa.
Forma anamorfa asessuata – Conidi:non vengono



prodotti.Il fungo si riproduce asessualmente tramite sclerozi.
Forma teleomorfa sessuata:è rappresentata da Thanatephorus. Basidi:sottili,gelatinosi, girati di 180° e senza setto fra l’epi- e il metabasidio; Basidiospore:prodotte raramente,con un nucleo
Sintomatologia e Ciclo biologico - Rhizoctonia causa la Rizottoniosi che attacca le radici delle plantule provocandone la necrosi. Sulle foglie delle piante sviluppate compaiono piccole aree circolari acquose e brune che poi si allargano.Sui frutti di pomodoro causa macchie brune che poi marciscono. Sulla pianta di Patata causa lesioni brune che si ricoprono di una patina bianca mentre sui tuberi si formano croste nere. Nella Barbabietola e Carota è responsabile del Mal vinato, che si manifesta con necrosi delle radici.Il fungo sopravvive alle condizioni avverse tramite gli sclerozi che contaminano il terreno e i detriti vegetali infetti.Gli sclerozi germinano formando ife che infettano le radici delle piante ospiti.Le ife penetrano nelle radici creandosi una via di entrata tramite la secrezione di enzimi.Le condizioni ambientali favorevoli allo sviluppo della malattia sono rappresentate da umidità e 25-28°C di temperatura.
Agenti eziologici della Ruggine
Uredinales

Specie di interesse orticolo – P.allii,P.arachidis, P.asparagi, P.porri,P.graminis.
Ciclo biologico - coinvolge in genere due piante ospiti diverse appartenenti anche a famiglie diverse e la formazione di spore di natura diversa. Le uredospore spinose,color ruggine e prodotte in pustole denominate uredosori (o uredini),si depositano sulla prima pianta ospite e,dopo la germinazione, si formano le teleutospore (o teliospore,con un setto) contenute in altre pustole denominate telia.Le teliospore sono in grado di sopravvivere all’inverno e germinando in primavera, danno origine a basidi e basidiospore. Le basidiospore non sono in grado di infettare l’ospite primario e vengono trasportate sulla pagina superiore delle foglie della pianta ospite secondaria dove germinano e producono un picnidio provvisto di un ostiolo con sostanze zuccherine che attraggono gli insetti. Nel picnidio vengono prodotti gameti maschili detti spermazi o picniospore che,trasportati dagli insetti fecondano ife recettive situate sulla pagina inferiore delle foglie dando origine ad una struttura denominata ecidio che lesiona le foglie del secondo ospite. Si sviluppano ecidiospore (o eciospore, spinose e pigmentate) che non sono in grado di infettare l’ospite secondario e vengono trasportate dal vento sulla pianta ospite primaria. Le ecidiospore germinando formano un micelio che produce uredospore ricominciando il ciclo.
In realtà il ciclo di vita dei funghi responsabili della Ruggine è variabile a seconda della specie e in particolare può essere:macrociclico quando il fungo produce tutti cinque stadi di spore o microciclico quando il fungo non li produce tutti (in genere manca lo stadio urediniale e/o ecidiale).In tutti i casi poi si hanno Ruggini autoiche se tutti gli stadi delll'infestazione avvengono nello stesso ospite o Ruggini eteroiche se gli stadi delll'infestazione avvengono su due diversi ospiti.
Morfologia delle spore - In Puccinia asparagi le ecidiospore sono globose o ovali,ialine e verrucose;le uredospore sono globose o ellittiche,con parete dorata e spinose; le teliospore sono arrotondate all'apice, ristrette al setto,con parete marrone.In Puccinia allii le uredospore sono ellittiche,ialine o gialle e spinose; le teliospore sono ovali o clavate,con un setto o senza,marroni-giallastre e lisce.
Sintomatologia - comparsa di piccole macchie bianche sulle nervature delle foglie per poi diventare pustole rosse. Le foglie quindi deperiscono e le piante colpite diventano rachitiche e muoiono.
Pucciniales
Uromyces spp.
Specie di interesse orticolo – U.appendiculatus, U. beticola, U.ciceris-arietini,U.phaseoli,U.pisi, U.viciae-fabae.
Ciclo biologico - Le uredospore vengono prodotte sulle foglie della pianta ospite in pustole (uredosori) arancio-marroni con un alone pallido e,dopo la germinazione,si formano altre pustole (telia)nero-marroni con un alone pallido contenenti le teleutospore.Le teleutospore sono in grado di sopravvivere all’inverno e germinando in primavera danno origine a basidi e basidiospore. La germinazione delle basidiospore produce un picnidio entro il quale vengono prodotte

le picniospore che fecondano ife recettive dando origine ad un ecidio contenenti le ecidiospore.Queste ultime si depositano come una polvere gialla e germinando formano un micelio che produce le uredospore ricominciando il ciclo.
In U.viciae-fabae e U.appendiculatus,la patologia è macrociclica e tutte le fasi avvengono sulle medesima pianta,cioè la malattia è anche autoica. In U.pisi la patologia è invece eteroica.
Morfologia delle spore - In U.viciae-fabae le uredospore sono globose,giallo-brune e spinose;le teliospore sono ellittiche o tonde e rossastre.In U.appendiculatus le uredospore sono ellittiche o sferiche, giallo-brune e spinose.In U.ciceris-arietini e uredospore sono globose,rossastre e spinose.
Uromyces si differenzia da Puccinia per il fatto che la prima possiede teleutospore senza setti.
Sintomatologia - comparsa di piccole macchie polverose arancioni-marroni alonate di giallo.Le foglie e gli steli deperiscono e le piante colpite diventano rachitiche e muoiono.
Urocystidales


Specie di interesse orticolo – U.cepulae, U.brassicae.
Ciclo biologico - Le uredospore vengono prodotte sulle foglie della pianta ospite in pustole (uredosori) arancio-marroni con un alone pallido e,dopo la germinazione,si formano altre pustole (telia)nero-marroni con un alone pallido contenenti le teleutospore.Dopo lo svernamento,le teleutospore danno origine a basidi e basidiospore che a loro volta, germinando, producono picniospore che fecondano ife recettive dando origine ad un micelio che infesta le giovani piante. Alcune ife del micelio danno origine a glomeruli detti sori contenenti nuove teleutospore che germinando producono uredospore ricominciando il ciclo.


Sintomatologia - comparsa di striature grigio-nere che lacerano le foglie facendo emergere i sori.
Cystofilobasidiales


Specie di interesse orticolo – Itersonilia perplexans
Agli apici delle ife emergenti dal micelio si trova una struttura che si può impropriamente definire basidio dal quale si diramano degli sterigmi rigidi a cui è ancorata una ballistospora. Quest’ultima viene espulsa violentemente dal basidio ma,a causa delle sue ridotte dimensioni, non raggiunge una particolare distanza.
Sintomatologia e Ciclo biologico - Phyllosticta causa il Cancro nero che affligge la Pastinaca,Carota e Prezzemolo. Si manifesta con lesioni prima brune e poi nere delle radici,in particolare a livello del


colletto. Le radici possono marcire totalmente. Spesso le lesioni si manifestano anche su foglie e fiori ed hanno un alone verde.macchie gialle con margini marroni che confluendo portano all'avvizimento delle foglie.Il fungo sopravvive alle condizioni avverse tramite le clamidospore svernanti nel terreno e si diffonde tramite le ballistospore trasportate dal vento. Le condizioni ambientali favorevoli allo sviluppo della malattia sono rappresentate da clima umido e fresco.
METODI DIAGNOSTOCI
Per diagnosticare con precisione una malattia crittogamica,occorre prendere in considerazione alcuni fattori basilari ed utilizzare alcuni metodi e strumenti opportuni. L'indagine prevede i seguenti passaggi:
- Osservazione dei sintomi che la pianta infettata manifesta nei suoi vari organi. In moltissimi casi questo è già sufficiente per almeno ipotizzare il tipo di patologia. Per esempio la comparsa di aree arrossate sulle foglie di Fragola è indice della presenza praticamente certa di Diplocarpon.
- Prelievo di un campione di tessuto malato ed utilizzo di un microscopio ottico al fine di osservare alcune caratteristiche distintive come la morfologia del micelio,dei corpi fruttiferi,delle spore,sclerozi,ecc.
- Eventuale coltivazione ''in vitro'' del fungo patogeno per ottenere una coltura pura.
- Eventuale utilizzo di ''chiavi dicotomiche'' che permettano di seguire uno schema che porti ad un risultato,che molto spesso però si limita alla individualizzazione del genere e non della specie del fungo (ma questo è più che sufficiente).
L'osservazione microscopica - tecnica
L'osservazione microscopica dei funghi non è particolarmente complessa sia per l'attrezzatura da utilizzare sia per il fatto che non richiede elevati ingrandimenti.L'unica difficoltà pratica è la preparazione del campione che deve essere di grandezza opportuna,in genere di modestissima quantità per il fatto che il micelio può essere talmente fitto da nascondere le spore,i conidi,ecc.Inoltre occorre prestare attenzione al fatto che nel campione possono essere presenti anche altri microrganismi.

Strumenti e materiali:
Microscopio ottico - non necessariamente professionale e ingrandimento di almeno 500x. In commercio sono in vendita microscopi digitali a basso costo che sono provvisti di telecamera per la visione dell'immagine sul monitor di un pc.
Vetrini porta-oggetti e copri-oggetti - convenzionali,ma ne esistono anche con una concavità nel centro che può essere utile per l'osservazione.
Aghi di siringa e pinzetta - per prelevare e sminuzzare il campione.
Contagocce- per erogare gocce d'acqua o di colorante.


Colorante - in genere si utilizza il lattofenolo-blu cotone. Il colorante permette una maggiore risoluzione dell'immagine che apparirebbe altrimenti più o meno trasparente e quindi di scarso valore diagnostico. Le osservazioni a fresco (senza colorante)si possono efficacemente eseguire se si possiede un microscopio a contrasto di fase,che è però professionale e costoso.

Esecuzione: con l'aiuto di un ago si deposita un pò di campione sul vetrino porta-oggetti; si copre il campione sul vetrino con una goccia di colorante; si copre con vetrino copri-oggetto e si asciuga il liquido che straborda con un pezzetto di carta assorbente; si osserva al microscopio.


①richiede un vetrino porta-oggetti con una concavità nel centro (vetrino di Koch).②All'interno della concavità del vetrino porta-oggetto viene posto il campione con una goccia di colorante.③ Intorno ai bordi della concavità si spalma un filo di silicone.④Si rovescia il vetrino porta-oggetti sulla goccia di campione, facendo aderire il silicone.⑤Si rovescia il tutto e ⑥⑦si passa all’osservazione al microscopio.
metodo del nastro adesivo
L'indagine colturale
Consiste nel ''coltivare'' il fungo patogeno in vitro allo scopo di osservarne lo sviluppo,identificarlo direttamente oppure tramite successiva indagine al microscopio. La tecnica presenta il vantaggio di offrire una visione macroscopica diretta del fungo e di ottenere una coltura pura da osservare al microscopio.Il limite della tecnica consiste però nel fatto che oltre al fungo di interesse si possono sviluppare altri funghi e/o batteri anche patogeni per l'uomo. Diversamente dall'indagine microscopica,l'indagine colturale obbliga a lavorare con attenzione. Fondamentale è la sterilizzazione di qualunque oggetto venga utilizzato,il lavaggio delle mani e la precauzione di toccare gli strumenti solo all'esterno e mai all'interno e/o all'imboccatura. Inoltre,quando possibile,occorre operare piuttosto velocemente in modo che l'esposizione all'aria sia minima.

Piastre di Petri
Ansa con punta di metallo: se di plastica monouso sono già sterili oppure sterilizzabile in acqua bollente.
Taglierino
Tubi di saggio con tappo a vite: necessariamente di vetro
Bunsen o fornelletto ad alcool: il fornelletto si può allestire oppure si può acquistarne uno a gas da campeggio.
Bilancia da cucina: non strettamente necessaria.
Becker di capacità diversa: sostituibili con altri contenitori non di plastica
Bacchetta di vetro: anche di metallo o plastica
Acqua distillata: quella dei ferri da stiro,non quella di rubinetto.
Terreno ("brodo" di coltura): quelli idonei sono rappresentati da
Dextrose Agar - è il substrato base per la coltura di funghi. E' agar arricchito con destrosio
Potato Dextrose Agar (PDA) - agar arricchito con destrosio (o zucchero) e fecola di patata. E' il terreno di coltura più utilizzato.
Sabourad Dextrose Agar - (Destrosio 20g, Agar 15g,Peptone 10g,Glicerina 5ml,Acqua distillata 1L)
Malt Extract Agar (MEA) - agar arricchito con estratti di cereali germogliati.
Sabouraud Maltose Agar - (Maltosio 20g, Agar 15g,Peptone 10g,Glicerina 5ml,Acqua distillata 1L)
Czapek’s agar - (Zucchero30g, Agar 15g,Sodio nitrato NaNO3 2g,Potassio fosfato K3PO41g,Magnesio solfato MgSO4 0,5g=500mg,Cloruro ferrico FeCl30,5g=500mg,Solfato ferroso FeSO40,01g=10mg,Acqua distillata 1L)
In commercio si possono trovare piastre di Petri contenenti il terreno di coltura,già sterili e pronte all'uso. Inoltre possono essere anche essere addizionate con l'antibiotico Cloramfenicolo in modo da scongiurare il più possibile lo sviluppo di batteri. Azione antibiotica hanno anche l'Acido citrico al 5% e l'Acido tartarico (5% di destrosio + 0,5% di acido tartarico).Nei prodotti commerciali viene spesso anche aggiunto Peptone,un preparato proteico.

- Prelevare un campione di tessuto vegetale infestato dal fungo (un piccolo quadrato di 1cm per lato)con un taglierino ben affilato e previamente sterilizzato in acqua bollente.
- Introdurre il campione in un tubo di saggio(sempre sterilizzato) e chiudere con il tappo.
- Consigliabile disinfettare il campione afferrato con una pinzetta (anch’essa
sterilizzata in acqua bollente)con ipoclorito di sodio al 2% (la comune candeggina)
per 2 minuti e sciacquare con acqua distillata.
- Introdurre il campione in un altro tubo di saggio(sempre sterilizzato) e chiudere con il tappo.
- Disinfettare il banco di lavoro dopo aver indossato i guanti monouso e lavare le mani
con i guanti indossati.
- Preparare il terreno di coltura prelevando una opportuna quantità pesata di prodotto in polvere e inserirla in un becker capiente (1 litro). Per pesare la giusta quantità si possono utilizzare tre modi:1)si posa la polvere su un sottile foglio di carta di peso trascurabile e si pesa sulla bilancia;si pone la polvere in un contenitore sterile precedentemente pesato e si pone sulla bilancia:peso della polvere= (peso polvere+recipiente) - peso recipiente.3) si può utilizzare una normale caraffa graduata da cucina. Il metodo non è accurato ma non necessita della bilancia.
- Aggiungere l’opportuna quantità di acqua distillata e con una bacchetta di vetro mescolare e disciogliere la polvere.
- Sterilizzare a bagnomaria la soluzione portando leggermente a bollore mescolando con la bacchetta
- Versare l’agar liquefatto in una piastra di Petri, precedentemente sterilizzata in acqua bollente e con il coperchio,riempiendola per metà e lentamente per evitare la formazione di bolle d’aria. Chiudere la piastra con il suo coperchio e attendere che l’agar solidifichi.
- Accendere il bunsen ed afferrare con una mano il tubo di saggio con il campione e con l’altra mano arroventare la punta dell’ansa. Svitare il tappo del tubo di saggio e passare alla fiamma più volte l’estremità superiore del tubo.
- Inserire l’ansa nel tubo e prelevare un frammento di campione.
- Inoculare il campione al centro della piastra di Petri con il terreno colturale.
- Tenere in incubazione a 25°C e al buio.
Occorre specificare che l'indagine colturale è efficace per i funghi saprofiti obbligati o facoltativi,non per quelli che sono patogeno obbligati.
La sterilizzazione a livello professionale si esegue in un dispositivo detto autoclave.A livello artigianale si può utilizzare una pentola a pressione:dopo aver letto le istruzioni d'uso della pentola,il terreno di coltura si sterilizza a 120°C, 15psi di pressione e per 15 minuti;le attrezzature a 120°C, 15psi di pressione e per 30 minuti.

Le Chiavi dicotomiche
Le Chiavi dicotomiche rappresentano uno schema,che,considerando determinate caratteristiche morfologiche,permettono di identificare procedendo per gradi e per esclusione,l'identificazione di un organismo. Per i funghi patogeni delle orticole,i caratteri maggiormente considerati sono:
- la presenza di ife senza setti(Oomiceti),con setti (Ascomiceti) e con setti e giunti a fibbia (Basidiomiceti).
- la tipologia e morfologia dei corpi fruttiferi (Sporangi,Picnidi,Cleistoteci,Periteci,Apoteci,Acervuli,Basidi,ecc)
- la morfologia delle spore (Conidi,Ascospore,Basidiospore,Zoospore,Clamidospore,ecc.)
- piante e organi infettati.





